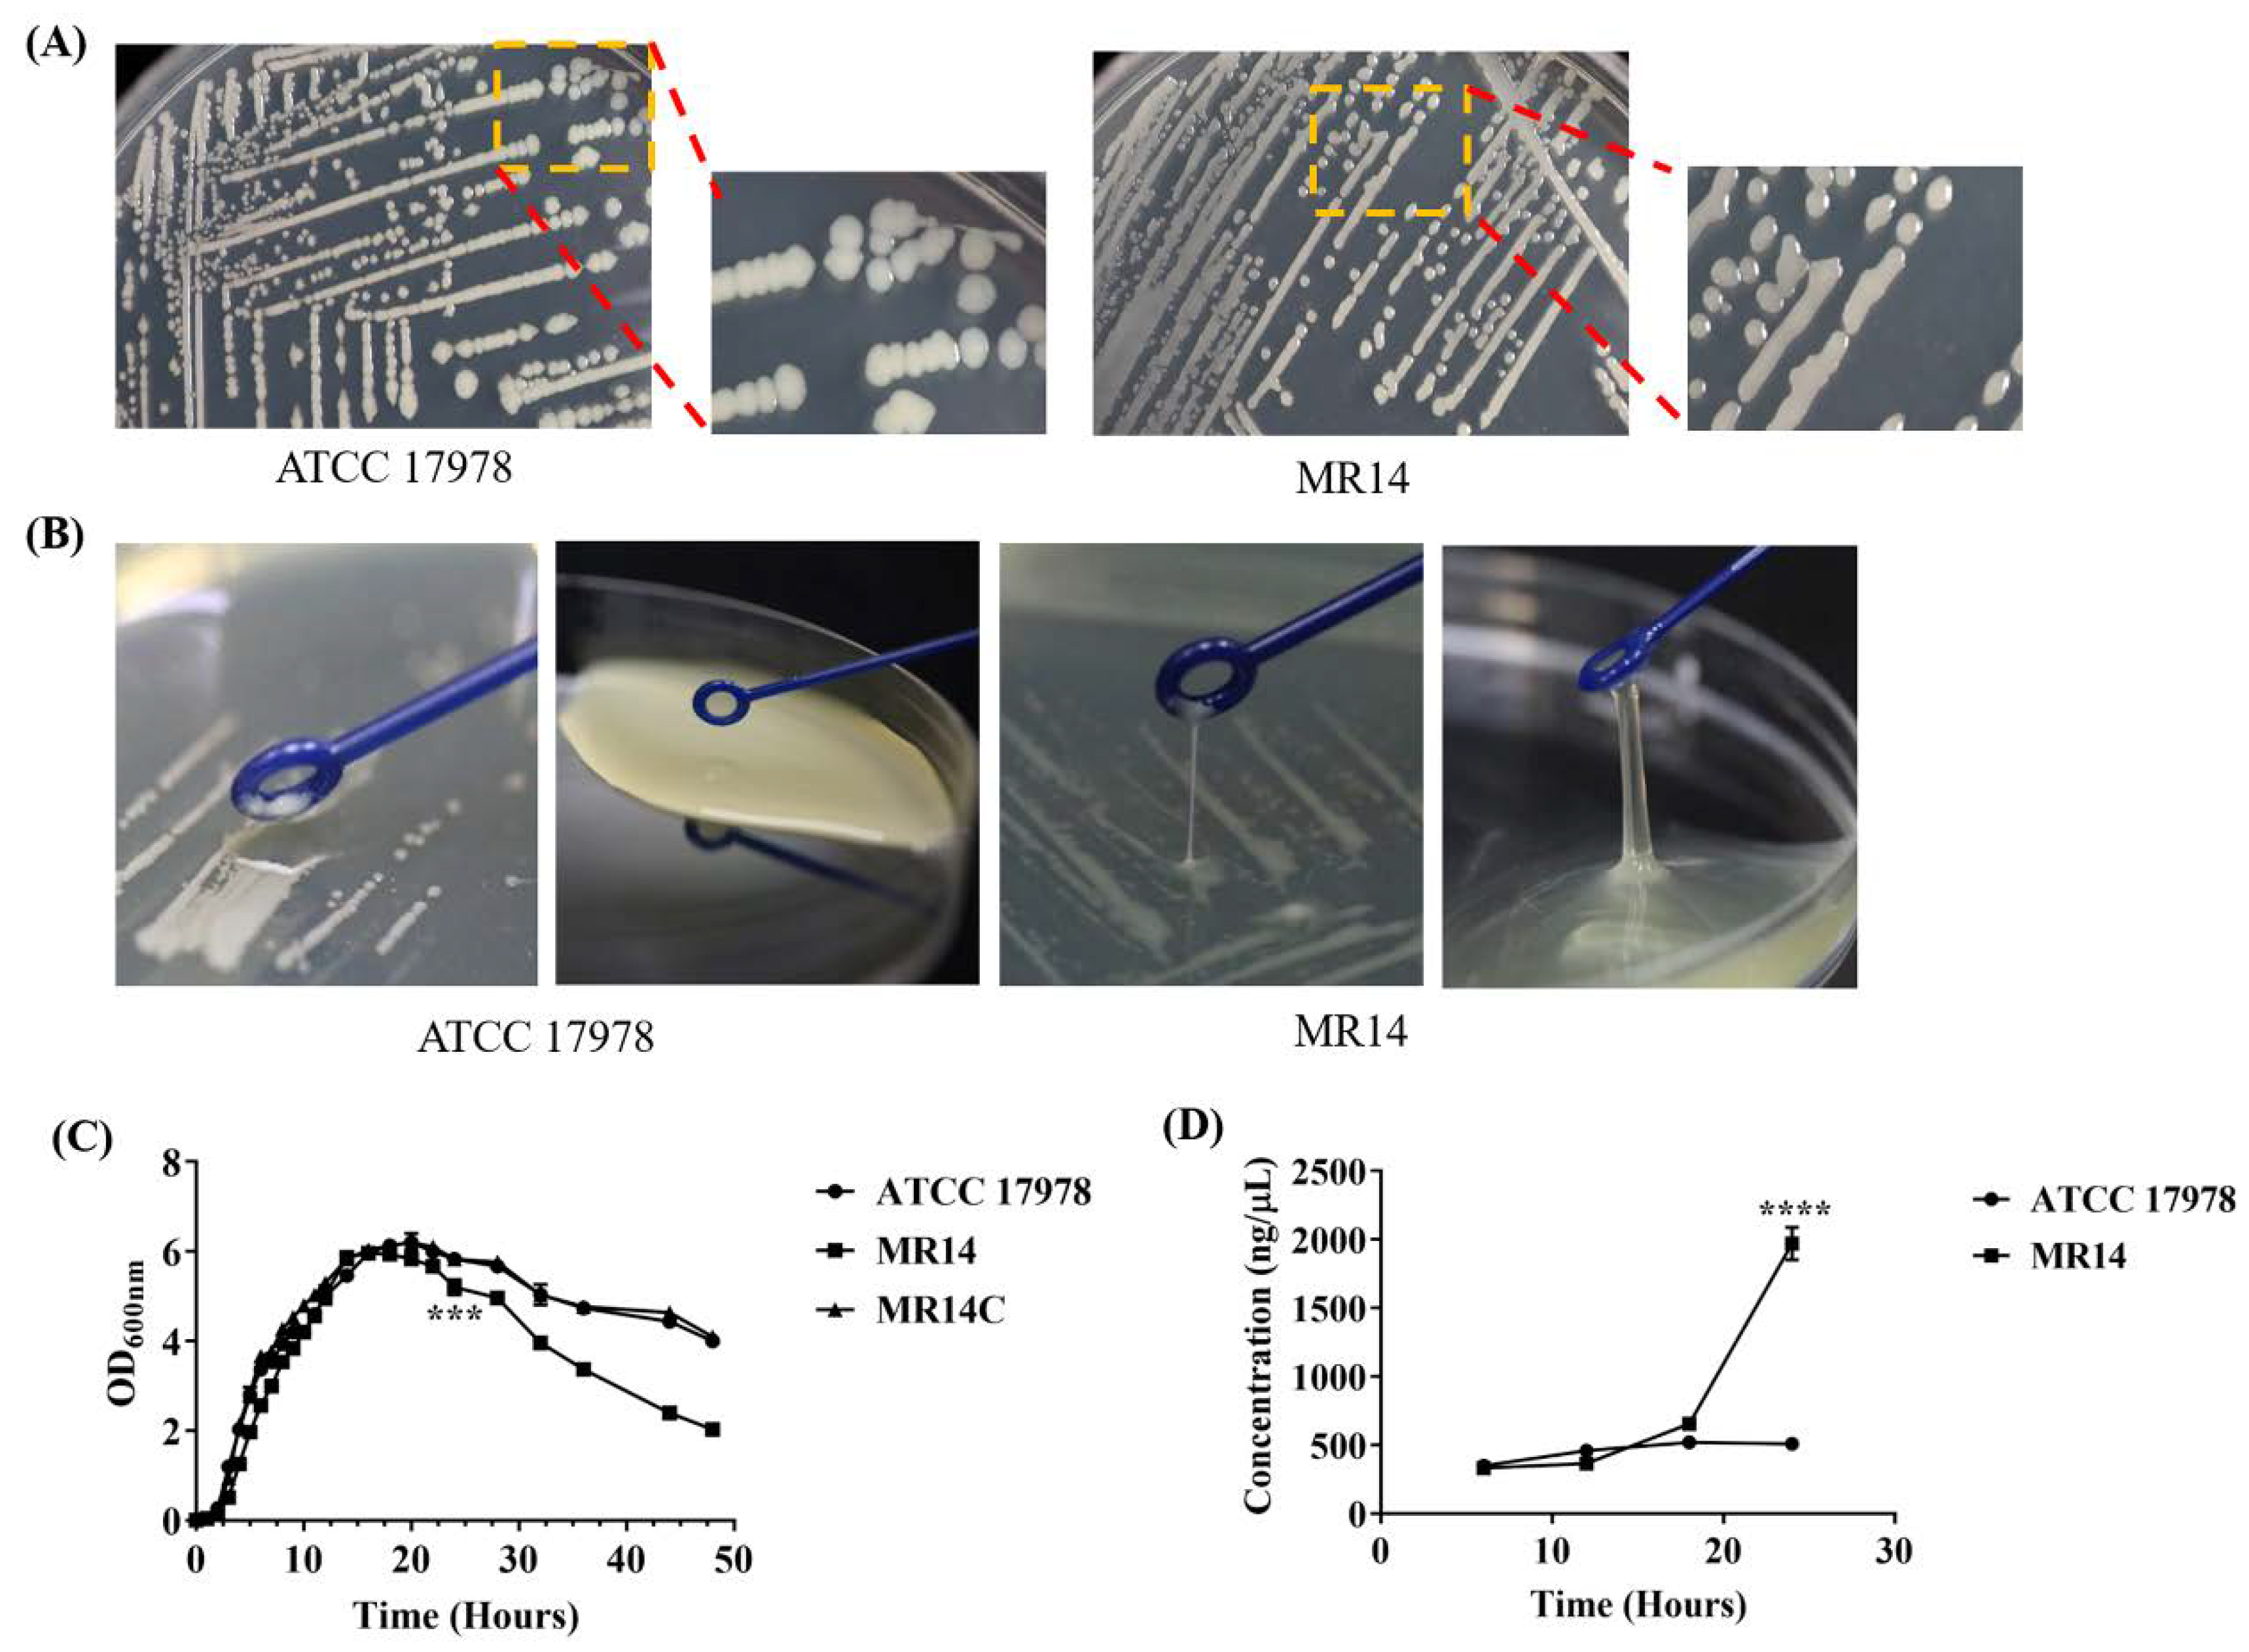
Pathogens 09 00322 g004 Pathogens 09 00322 g004

Mutation of the Carboxy-Terminal Processing Protease in Acinetobacter baumannii Affects Motility, Leads to Loss of Membrane Integrity, and Reduces Virulence
Abstract
1. Introduction
2. Results
2.1. Carboxy-Terminal Processing Protease (Ctp) Involvement in A. baumannii Motility
2.2. Complementation of MR14 with Ctp Gene Can Restore Twitching and Surface-Associated Motility
2.3. MR14 Showed Mucoidy and Sticky Phenotype
2.4. The Ctp Gene is Essential for Maintaining Membrane Integrity
2.5. The Ctp Gene Mutation Induces Cell Lysis
2.6. The Ctp Gene Contributes to Tolerance against External Stresses
2.7. The Ctp Gene Contributes to Virulence in A. baumannii
3. Discussion
4. Materials and Methods
4.1. Bacterial Strains, Plasmids, Primers, and Growth Conditions
4.2. Mutagenesis of A. baumannii ATCC 17978 by the Mini-Tn10:nptII Transposon Method
4.3. Motility Assay
4.4. Identification of DNA Sequences at Transposon Insertion Site
4.5. Construction of the A1S_0493 Complementation Strain
4.6. Purification of eDNA
4.7. TEM and SEM Analysis
4.8. Cell Viability Assay
4.9. Stress Tolerance Assays
4.10. Cell Surface Hydrophobicity Test
4.11. Adhesion and Invasion Assays
4.12. Zebrafish Model for Infection
5. Conclusions
Author Contributions
Funding
Acknowledgments
Conflicts of Interest
References
- Chen, C.T.; Wang, Y.C.; Kuo, S.C.; Shih, F.H.; Chen, T.L.; How, C.K.; Yang, Y.S.; Lee, Y.T. Community-acquired bloodstream infections caused by Acinetobacter baumannii: A matched case–control study. J. Microbiol. Immunol. Infect. 2018, 51, 629–635. [Google Scholar] [CrossRef] [PubMed]
- Maragakis, L.L.; Perl, T.M. Antimicrobial Resistance: Acinetobacter baumannii: Epidemiology, Antimicrobial Resistance, and Treatment Options. Clin. Infect. Dis. 2008, 46, 1254–1263. [Google Scholar] [CrossRef] [PubMed]
- Al-Anazi, K.A.; Al-Jasser, A.M. Infections caused by Acinetobacter baumannii in recipients of hematopoietic stem cell transplantation. Front. Oncol. 2014, 4, 186. [Google Scholar] [CrossRef] [PubMed]
- Cerqueira, G.M.; Peleg, A.Y. Insights into Acinetobacter baumannii pathogenicity. IUBMB Life 2011, 63, 1055–1060. [Google Scholar] [CrossRef]
- Josenhans, C.; Suerbaum, S. The role of motility as a virulence factor in bacteria. Int. J. Med. Microbiol. 2002, 291, 605–614. [Google Scholar] [CrossRef]
- Clemmer, K.M.; Bonomo, R.A.; Rather, P.N. Genetic analysis of surface motility in Acinetobacter baumannii. Microbiology 2011, 157, 2534–2544. [Google Scholar] [CrossRef]
- Antunes, L.C.S.; Imperi, F.; Carattoli, A.; Visca, P. Deciphering the Multifactorial Nature of Acinetobacter baumannii Pathogenicity. PLoS ONE 2011, 6, e22674. [Google Scholar] [CrossRef]
- De Silva, P.M.; Kumar, A. Effect of Sodium Chloride on Surface-Associated Motility of Acinetobacter baumannii and the Role of AdeRS Two-Component System. J. Membr. Biol. 2018, 251, 5–13. [Google Scholar] [CrossRef]
- Barker, J.; Maxted, H. Observations on the growth and movement of Acinetobacter on semi solid media. J. Med. Microbiol. 1975, 8, 443–446. [Google Scholar] [CrossRef]
- Leong, C.G.; Bloomfield, R.A.; Boyd, C.A.; Dornbusch, A.J.; Lieber, L.; Liu, F.; Owen, A.; Slay, E.; Lang, K.M.; Lostroh, C.P. The role of core and accessory type IV pilus genes in natural transformation and twitching motility in the bacterium Acinetobacter baylyi. PLoS ONE 2017, 12, e0182139. [Google Scholar] [CrossRef]
- Harding, C.M.; Tracy, E.N.; Carruthers, M.D.; Rather, P.N.; Actis, L.A.; Munson, R.S. Acinetobacter baumannii strain M2 produces type IV Pili which play a role in natural transformation and twitching motility but not surface-associated motility. MBio 2013, 4, e00360-13. [Google Scholar] [CrossRef]
- Wood, C.R.; Ohneck, E.J.; Edelmann, R.E.; Actis, L.A. A light-regulated type I pilus contributes to Acinetobacter baumannii biofilm, motility, and virulence functions. Infect. Immun. 2018, 86, e00442-18. [Google Scholar] [CrossRef] [PubMed]
- McQueary, C.N.; Kirkup, B.C.; Si, Y.; Barlow, M.; Actis, L.A.; Craft, D.W.; Zurawski, D.V. Extracellular stress and lipopolysaccharide modulate Acinetobacter baumannii surface-associated motility. J. Microbiol. 2012, 50, 434–443. [Google Scholar] [CrossRef] [PubMed]
- Henrichsen, J. The Influence of Changes in The Environment on Twitching Motility. Acta Pathol. Microbiol. Scand. Sect. B Microbiol. 1975, 83B, 179–186. [Google Scholar] [CrossRef] [PubMed]
- Mattick, J.S. Type IV Pili and Twitching Motility. Annu. Rev. Microbiol. 2002, 56, 289–314. [Google Scholar] [CrossRef] [PubMed]
- Nolan, L.M.; Whitchurch, C.B.; Barquist, L.; Katrib, M.; Boinett, C.J.; Mayho, M.; Goulding, D.; Charles, I.G.; Filloux, A.; Parkhill, J.; et al. A global genomic approach uncovers novel components for twitching motility-mediated biofilm expansion in Pseudomonas aeruginosa. Microb. Genom. 2018, 4, e000229. [Google Scholar] [CrossRef]
- Rajagopala, S.V.; Titz, B.; Goll, J.; Parrish, J.R.; Wohlbold, K.; McKevitt, M.T.; Palzkill, T.; Mori, H.; Finley, R.L.; Uetz, P. The protein network of bacterial motility. Mol. Syst. Biol. 2007, 3. [Google Scholar] [CrossRef]
- Piepenbrink, K.H.; Lillehoj, E.; Harding, C.M.; Labonte, J.W.; Zuo, X.; Rapp, C.A.; Munson, R.S.; Goldblum, S.E.; Feldman, M.F.; Gray, J.J.; et al. Structural diversity in the type IV Pili of multidrug-resistant acinetobacter. J. Biol. Chem. 2016, 291, 22924–22935. [Google Scholar] [CrossRef]
- Young, G.M.; Badger, J.L.; Miller, V.L. Motility is required to initiate host cell invasion by Yersinia enterocolitica. Infect. Immun. 2000, 68, 4323–4326. [Google Scholar] [CrossRef] [PubMed][Green Version]
- Tamar, E.; Koler, M.; Vaknin, A. The role of motility and chemotaxis in the bacterial colonization of protected surfaces. Sci. Rep. 2016, 6, 1–11. [Google Scholar] [CrossRef] [PubMed]
- Kurmasheva, N.; Vorobiev, V.; Sharipova, M.; Efremova, T.; Mardanova, A. The Potential Virulence Factors of Providencia stuartii: Motility, Adherence, and Invasion. Biomed Res. Int. 2018, 2018. [Google Scholar] [CrossRef] [PubMed]
- Vijayakumar, S.; Rajenderan, S.; Laishram, S.; Anandan, S.; Balaji, V.; Biswas, I. Biofilm Formation and Motility Depend on the Nature of the Acinetobacter baumannii Clinical Isolates. Front. Public Heal. 2016, 4, 105. [Google Scholar] [CrossRef] [PubMed]
- Skiebe, E.; De Berardinis, V.; Morczinek, P.; Kerrinnes, T.; Faber, F.; Lepka, D.; Hammer, B.; Zimmermann, O.; Ziesing, S.; Wichelhaus, T.A.; et al. Surface-associated motility, a common trait of clinical isolates of Acinetobacter baumannii, depends on 1,3-diaminopropane. Int. J. Med. Microbiol. 2012, 302, 117–128. [Google Scholar] [CrossRef] [PubMed][Green Version]
- Smithies, W.R.; Gibbons, N.E. The deoxyribose nucleic acid slime layer of some halophilic bacteria. Can. J. Microbiol. 1955, 1, 614–621. [Google Scholar] [CrossRef] [PubMed]
- Das, T.; Sehar, S.; Koop, L.; Wong, Y.K.; Ahmed, S.; Siddiqui, K.S.; Manefield, M. Influence of calcium in extracellular DNA mediated bacterial aggregation and biofilm formation. PLoS ONE 2014, 9, e91935. [Google Scholar] [CrossRef] [PubMed]
- Krasowska, A.; Sigler, K. How microorganisms use hydrophobicity and what does this mean for human needs? Front. Cell. Infect. Microbiol. 2014, 4, 112. [Google Scholar] [CrossRef]
- Zita, A.; Hermansson, M. Determination of bacterial cell surface hydrophobicity of single cells in cultures and in wastewater in situ. FEMS Microbiol. Lett. 1997, 152, 299–306. [Google Scholar] [CrossRef] [PubMed]
- Wang, C.Y.; Wang, S.W.; Huang, W.C.; Kim, K.S.; Chang, N.S.; Wang, Y.H.; Wu, M.H.; Teng, C.H. Prc contributes to Escherichia coli evasion of classical complement-mediated serum killing. Infect. Immun. 2012, 80, 3399–3409. [Google Scholar] [CrossRef]
- Lahesaare, A.; Ainelo, H.; Teppo, A.; Kivisaar, M.; Heipieper, H.J.; Teras, R. LapF and Its Regulation by Fis Affect the Cell Surface Hydrophobicity of Pseudomonas putida. PLoS ONE 2016, 11, e0166078. [Google Scholar] [CrossRef]
- Noh, J.G.; Jeon, H.E.; So, J.S.; Chang, W.S. Effects of the Bradyrhizobium japonicum waaL (rfaL) gene on hydrophobicity, motility, stress tolerance, and symbiotic relationship with soybeans. Int. J. Mol. Sci. 2015, 16, 16778–16791. [Google Scholar] [CrossRef]
- Choi, C.H.; Lee, J.S.; Lee, Y.C.; Park, T.I.; Lee, J.C. Acinetobacter baumannii invades epithelial cells and outer membrane protein A mediates interactions with epithelial cells. BMC Microbiol. 2008, 8, 216. [Google Scholar] [CrossRef] [PubMed]
- Skerniškyte, J.; Krasauskas, R.; Péchoux, C.; Kulakauskas, S.; Armalyte, J.; Sužiedeliene, E. Surface-related features and virulence among Acinetobacter Baumannii clinical isolates belonging to international clones i and II. Front. Microbiol. 2019, 10, 3116. [Google Scholar] [CrossRef] [PubMed]
- Carroll, R.K.; Rivera, F.E.; Cavaco, C.K.; Johnson, G.M.; Martin, D.; Shaw, L.N. The lone S41 family C-terminal processing protease in Staphylococcus aureus is localized to the cell wall and contributes to virulence. Microbiology 2014, 160, 1737–1748. [Google Scholar] [CrossRef] [PubMed]
- Bandara, A.B.; Sriranganathan, N.; Schurig, G.G.; Boyle, S.M. Carboxyl-terminal protease regulates Brucella suis morphology in culture and persistence in macrophages and mice. J. Bacteriol. 2005, 187, 5767–5775. [Google Scholar] [CrossRef] [PubMed]
- Lad, S.P.; Li, J.; Da Silva Correia, J.; Pan, Q.; Gadwal, S.; Ulevitch, R.J.; Li, E. Cleavage of p65/RelA of the NF-κB pathway by Chlamydia. Proc. Natl. Acad. Sci. USA 2007, 104, 2933–2938. [Google Scholar] [CrossRef]
- Hoge, R.; Laschinski, M.; Jaeger, K.-E.; Wilhelm, S.; Rosenau, F. The subcellular localization of a C-terminal processing protease in Pseudomonas aeruginosa. FEMS Microbiol. Lett. 2011, 316, 23–30. [Google Scholar] [CrossRef]
- Bandara, A.B.; DeShazer, D.; Inzana, T.J.; Sriranganathan, N.; Schurig, G.G.; Boyle, S.M. A disruption of ctpA encoding carboxy-terminal protease attenuates Burkholderia mallei and induces partial protection in CD1 mice. Microb. Pathog. 2008, 45, 207–216. [Google Scholar] [CrossRef]
- Ostberg, Y.; Carroll, J.A.; Pinne, M.; Krum, J.G.; Rosa, P.; Bergström, S. Pleiotropic effects of inactivating a carboxyl-terminal protease, CtpA, in Borrelia burgdorferi. J. Bacteriol. 2004, 186, 2074–2084. [Google Scholar] [CrossRef]
- Pan, Q.; Losick, R.; Rudner, D.Z. A second PDZ-containing serine protease contributes to activation of the sporulation transcription factor sigmaK in Bacillus subtilis. J. Bacteriol. 2003, 185, 6051–6056. [Google Scholar] [CrossRef]
- Li, Y.; Pan, Y.; She, Q.; Chen, L. A novel carboxyl-terminal protease derived from Paenibacillus lautus CHN26 exhibiting high activities at multiple sites of substrates. BMC Biotechnol. 2013, 13, 89. [Google Scholar] [CrossRef]
- Hazan, R.; Que, Y.A.; Maura, D.; Strobel, B.; Majcherczyk, P.A.; Hopper, L.R.; Wilbur, D.J.; Hreha, T.N.; Barquera, B.; Rahme, L.G. Auto Poisoning of the Respiratory Chain by a Quorum-Sensing-Regulated Molecule Favors Biofilm Formation and Antibiotic Tolerance. Curr. Biol. 2016, 26, 195–206. [Google Scholar] [CrossRef] [PubMed]
- Mutschler, H.; Gebhardt, M.; Shoeman, R.L.; Meinhart, A. A Novel Mechanism of Programmed Cell Death in Bacteria by Toxin–Antitoxin Systems Corrupts Peptidoglycan Synthesis. PLoS Biol. 2011, 9, e1001033. [Google Scholar] [CrossRef]
- Schauer, K.; Lehner, A.; Dietrich, R.; Kleinsteuber, I.; Canals, R.; Zurfluh, K.; Weiner, K.; Märtlbauer, E. A Cronobacter turicensis O1 antigen-specific monoclonal antibody inhibits bacterial motility and entry into epithelial cells. Infect. Immun. 2015, 83, 876–887. [Google Scholar] [CrossRef][Green Version]
- Jun, D.; Minic, Z.; Bhat, S.V.; Vanderlinde, E.M.; Yost, C.K.; Babu, M.; Dahms, T.E.S. Metabolic adaptation of a C-terminal protease A-deficient Rhizobium leguminosarum in response to loss of nutrient transport. Front. Microbiol. 2018, 8, 2017. [Google Scholar] [CrossRef]
- Tuchscherr, L.; Kreis, C.A.; Hoerr, V.; Flint, L.; Hachmeister, M.; Geraci, J.; Bremer-Streck, S.; Kiehntopf, M.; Medina, E.; Kribus, M.; et al. Staphylococcus aureus develops increased resistance to antibiotics by forming dynamic small colony variants during chronic osteomyelitis. J. Antimicrob. Chemother. 2016, 71, 438–448. [Google Scholar] [CrossRef]
- Kahl, B.C.; Becker, K. Clinical Significance and Pathogenesis of Staphylococcal Small Colony. Am. Soc. Microbiol. 2016, 29, 401–427. [Google Scholar]
- Castanheira, S.; Cestero, J.J.; García-Del Portillo, F.; Graciela Pucciarelli, M. Two distinct penicillin binding proteins promote cell division in different salmonella lifestyles. Microb. Cell 2018, 5, 165–168. [Google Scholar] [CrossRef]
- Sassine, J.; Xu, M.; Sidiq, K.R.; Emmins, R.; Errington, J.; Daniel, R.A. Functional redundancy of division specific penicillin-binding proteins in Bacillus subtilis. Mol. Microbiol. 2017, 106, 304–318. [Google Scholar] [CrossRef] [PubMed]
- Hara, H.; Yamamoto, Y.; Higashitani, A.; Suzuki, H.; Nishimura, Y. Cloning, mapping, and characterization of the Escherichia coli prc gene, which is involved in C-terminal processing of penicillin-binding protein 3. J. Bacteriol. 1991, 173, 4799–4813. [Google Scholar] [CrossRef]
- Singh, S.K.; Parveen, S.; SaiSree, L.; Reddy, M. Regulated proteolysis of a cross-link-specific peptidoglycan hydrolase contributes to bacterial morphogenesis. Proc. Natl. Acad. Sci. USA 2015, 112, 10956–10961. [Google Scholar] [CrossRef]
- Hill, M.; Deghmane, A.E.; Segovia, M.; Zarantonelli, M.L.; Tilly, G.; Blancou, P.; Bériou, G.; Josien, R.; Anegon, I.; Hong, E.; et al. Penicillin binding proteins as danger signals: Meningococcal penicillin binding protein 2 activates dendritic cells through toll-like receptor 4. PLoS ONE 2011, 6, e23995. [Google Scholar] [CrossRef] [PubMed]
- Keiler, K.C.; Silber, K.R.; Downard, K.M.; Papayannopoulos, I.A.; Biemann, K.; Sauer, R.T. C-terminal specific protein degradation: Activity and substrate specificity of the Tsp protease. Protein Sci. 1995, 4, 1507–1515. [Google Scholar] [CrossRef] [PubMed]
- Silber, K.R.; Keiler, K.C.; Sauer, R.T. Tsp: A Tail-Specific Protease that Selectively Degrades Proteins with Nonpolar C Termini. Proc. Natl. Acad. Sci. USA 1992, 89, 295–299. [Google Scholar] [CrossRef] [PubMed]
- Pinne, M.; Denker, K.; Nilsson, E.; Benz, R.; Bergström, S. The BBA01 protein, a member of paralog family 48 from Borrelia burgdorferi, is potentially interchangeable with the channel-forming protein P13. J. Bacteriol. 2006, 188, 4207–4217. [Google Scholar] [CrossRef] [PubMed][Green Version]
- Kumru, O.S.; Bunikis, I.; Sorokina, I.; Bergström, S.; Zückert, W.R. Specificity and role of the Borrelia burgdorferi CtpA protease in outer membrane protein processing. J. Bacteriol. 2011, 193, 5759–5765. [Google Scholar] [CrossRef]
- Kariu, T.; Sharma, K.; Singh, P.; Smith, A.A.; Backstedt, B.; Buyuktanir, O.; Pal, U. BB0323 and novel virulence determinant BB0238: Borrelia burgdorferi proteins that interact with and stabilize each other and are critical for infectivity. J. Infect. Dis. 2015, 211, 462–471. [Google Scholar] [CrossRef] [PubMed]
- Pal, U.; Yang, X.; Chen, M.; Bockenstedt, L.K.; Anderson, J.F.; Flavell, R.A.; Norgard, M.V.; Fikrig, E. OspC facilitates Borrelia burgdorferi invasion of Ixodes scapularis salivary glands. J. Clin. Invest. 2004, 113, 220–230. [Google Scholar] [CrossRef] [PubMed]
- Huang, W.C.; Lin, C.Y.; Hashimoto, M.; Wu, J.J.; Wang, M.C.; Lin, W.H.; Chen, C.S.; Teng, C.H. The role of the bacterial protease Prc in the uropathogenesis of extraintestinal pathogenic Escherichia coli. J. Biomed. Sci. 2020, 27, 14. [Google Scholar] [CrossRef]
- Gilbert, K.B.; Vanderlinde, E.M.; Yost, C.K. Mutagenesis of the carboxy terminal protease CtpA decreases desiccation tolerance in Rhizobium leguminosarum. FEMS Microbiol. Lett. 2007, 272, 65–74. [Google Scholar] [CrossRef]
- Mitchell, S.J.; Minnick, M.F. A carboxy-terminal processing protease gene is located immediately upstream of the invasion-associated locus from Bartonella bacilliformis. Microbiology 1997, 143, 1221–1233. [Google Scholar] [CrossRef]
- Baumler, A.J.; Kusters, J.G.; Stojiljkovic, I.; Heffron, F. Salmonella typhimurium loci involved in survival within macrophages. Infect. Immun. 1994, 62, 1623–1630. [Google Scholar] [CrossRef]
- Keiler, K.C.; Sauer, R.T. Sequence Determinants of C-terminal Substrate Recognition by the Tsp Protease. J. Biol. Chem. 1996, 271, 2589–2593. [Google Scholar] [CrossRef] [PubMed]
- Gohl, O.; Friedrich, A.; Hoppert, M.; Averhoff, B. The thin pili of Acinetobacter sp. strain BD413 mediate adhesion to biotic and abiotic surfaces. Appl. Environ. Microbiol. 2006, 72, 1394–1401. [Google Scholar] [CrossRef] [PubMed]
- Lee, J.C.; Koerten, H.; van den Broek, P.; Beekhuizen, H.; Wolterbeek, R.; van den Barselaar, M.; van der Reijden, T.; van der Meer, J.; van de Gevel, J.; Dijkshoorn, L. Adherence of Acinetobacter baumannii strains to human bronchial epithelial cells. Res. Microbiol. 2006, 157, 360–366. [Google Scholar] [CrossRef] [PubMed]
- Skerniškyte, J.; Karazijaite, E.; Deschamps, J.; Krasauskas, R.; Briandet, R.; Sužiedeliene, E. The mutation of conservative Asp268 residue in the peptidoglycan-associated domain of the OmpA protein affects multiple Acinetobacter baumannii virulence characteristics. Molecules 2019, 24, 1972. [Google Scholar] [CrossRef] [PubMed]
- Keiler, K.C.; Sauer, R.T. Identification of Active Site Residues of the Tsp Protease. J. Biol. Chem. 1995, 270, 28864–28868. [Google Scholar] [CrossRef] [PubMed]
- Chueh, C.K.; Som, N.; Ke, L.C.; Ho, M.R.; Reddy, M.; Chang, C.I. Structural basis for the differential regulatory roles of the PDZ domain in C-Terminal processing proteases. MBio 2019, 10, e01129-19. [Google Scholar] [CrossRef]
- Choi, C.H.; Hyun, S.H.; Lee, J.Y.; Lee, J.S.; Lee, Y.S.; Kim, S.A.; Chae, J.-P.; Yoo, S.M.; Lee, J.C. Acinetobacter baumannii outer membrane protein A targets the nucleus and induces cytotoxicity. Cell. Microbiol. 2007, 0, 070907125921001. [Google Scholar] [CrossRef]
- Yun, S.H.; Park, E.C.; Lee, S.Y.; Lee, H.; Choi, C.W.; Yi, Y.S.; Ro, H.J.; Lee, J.C.; Jun, S.; Kim, H.Y.; et al. Antibiotic treatment modulates protein components of cytotoxic outer membrane vesicles of multidrug-resistant clinical strain, Acinetobacter baumannii DU202. Clin. Proteomics 2018, 15, 28. [Google Scholar] [CrossRef]
- Moreno-Cinos, C.; Goossens, K.; Salado, I.G.; Van Der Veken, P.; De Winter, H.; Augustyns, K. ClpP protease, a promising antimicrobial target. Int. J. Mol. Sci. 2019, 20, 2232. [Google Scholar] [CrossRef]
- Sassetti, E.; Cruz, C.D.; Tammela, P.; Winterhalter, M.; Augustyns, K.; Gribbon, P.; Windshügel, B. Identification and characterization of approved drugs and drug-like compounds as covalent Escherichia coli clpp inhibitors. Int. J. Mol. Sci. 2019, 20, 2686. [Google Scholar] [CrossRef]
- Sahu, P.K.; Iyer, P.S.; Oak, A.M.; Pardesi, K.R.; Chopade, B.A. Characterization of eDNA from the clinical strain acinetobacter baumannii AIIMS 7 and its role in biofilm formation. Sci. World J. 2012, 2012, 973436. [Google Scholar] [CrossRef]
- Kuo, H.Y.; Chao, H.H.; Liao, P.C.; Hsu, L.; Chang, K.C.; Tung, C.H.; Chen, C.H.; Liou, M.L. Functional characterization of Acinetobacter baumannii Lacking the RNA chaperone Hfq. Front. Microbiol. 2017, 8, 2068. [Google Scholar] [CrossRef] [PubMed]
- Kurinčič, M.; Jeršek, B.; Klančnik, A.; Možina, S.S.; Fink, R.; Dražić, G.; Raspor, P.; Bohinc, K. Effects of natural antimicrobials on bacterial cell hydrophobicity, adhesion, and zeta potential. Arh. Hig. Rada Toksikol. 2016, 67, 39–45. [Google Scholar] [CrossRef] [PubMed]
- Bhuiyan, M.S.; Ellett, F.; Murray, G.L.; Kostoulias, X.; Cerqueira, G.M.; Schulze, K.E.; Maifiah, M.H.M.; Li, J.; Creek, D.J.; Lieschke, G.J.; et al. Acinetobacter baumannii phenylacetic acid metabolism influences infection outcome through a direct effect on neutrophil chemotaxis. Proc. Natl. Acad. Sci. USA 2016, 113, 9599–9604. [Google Scholar] [CrossRef] [PubMed]

| Strains or Plasmid | Genotype and/or Characteristics | Source |
|---|---|---|
| Strains | ||
| E. coli SM10λpir | thiL thrL leuB6 supE44 tonA21 lacY1 for Tn10 transposon mutagenesis | |
| ATCC 17978 | Wild-type strain | ATCC |
| MR14 | Containing ctp gene mutation | This study |
| MR14C | Containing ctp gene complementation | This study |
| E. coli Top10 | For the recombinant DNA method | Invitrogen |
| Plasmids | ||
| pBSL180 | Kmr Mini-Tn10 containing vector; R6K ori mobRP4 | NBRP (NIG, Japan) |
| pTZ57R/T | Apr PCR cloning vector | Fermentas |
| pABCL_llb | Aprr Derived from pET28a, including MCS and N, C-terminal 6XHis tag for complementation | - |
| Primers | Sequence (5’-3’) | DNA Template | Restriction Site |
|---|---|---|---|
| FP-nptII | AGATGGATTGCACGCAGG | pBSL180 | - |
| RP-nptII | CCACAGTCGATGAATCCAGA | Tn10 transposon | - |
| nptII-iF | GCCTTCTATCGCCTTCTTGAG | pBSL180 | - |
| nptII-iR | TACGTGTTCCGCTTCCTTTAG | pBSL180 | - |
| 0493F | GGATCCCACCCAAGGAAGTATTAAG | ATCC 17978 | BamHI |
| 0493R | GTCGACTGACACTTTGATGATAAATGC | ATCC 17978 | SalI |
| FP-0493 | GGATCCGCTGTTTCTCAATCGATCC | ATCC 17978 | BamHI |
| RP-0493 | GTCGACGTTCTGCAATTTCGCATA | ATCC 17978 | SalI |
© 2020 by the authors. Licensee MDPI, Basel, Switzerland. This article is an open access article distributed under the terms and conditions of the Creative Commons Attribution (CC BY) license (http://creativecommons.org/licenses/by/4.0/).
Share and Cite
Roy, R.; You, R.-I.; Lin, M.-D.; Lin, N.-T. Mutation of the Carboxy-Terminal Processing Protease in Acinetobacter baumannii Affects Motility, Leads to Loss of Membrane Integrity, and Reduces Virulence. Pathogens 2020, 9, 322. https://doi.org/10.3390/pathogens9050322
Roy R, You R-I, Lin M-D, Lin N-T. Mutation of the Carboxy-Terminal Processing Protease in Acinetobacter baumannii Affects Motility, Leads to Loss of Membrane Integrity, and Reduces Virulence. Pathogens. 2020; 9(5):322. https://doi.org/10.3390/pathogens9050322
Chicago/Turabian StyleRoy, Rakesh, Ren-In You, Ming-Der Lin, and Nien-Tsung Lin. 2020. "Mutation of the Carboxy-Terminal Processing Protease in Acinetobacter baumannii Affects Motility, Leads to Loss of Membrane Integrity, and Reduces Virulence" Pathogens 9, no. 5: 322. https://doi.org/10.3390/pathogens9050322
APA StyleRoy, R., You, R.-I., Lin, M.-D., & Lin, N.-T. (2020). Mutation of the Carboxy-Terminal Processing Protease in Acinetobacter baumannii Affects Motility, Leads to Loss of Membrane Integrity, and Reduces Virulence. Pathogens, 9(5), 322. https://doi.org/10.3390/pathogens9050322

